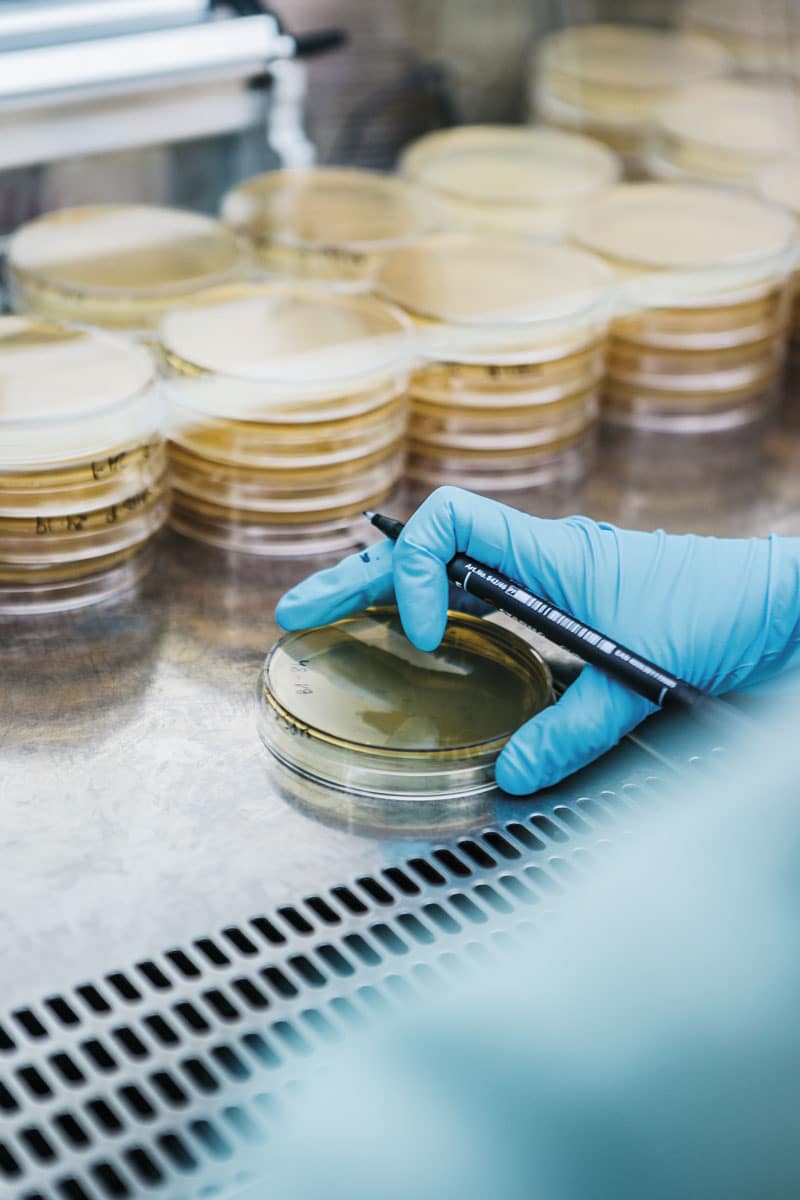

Análisis microbiológico
La contaminación microbiológica, sobre todo la bacteriana, es la causa más común de problemas sanitarios derivados de la alimentación. Cualquier alimento debería estar, en condiciones ideales, libre de la presencia de microorganismos patógenos. Pero conseguirlo no es siempre posible. Además de las medidas preventivas para evitar la contaminación de los productos y la proliferación de microrganismos patógenos en los mismos, el control analítico es una herramienta insustituible para asegurar la inocuidad de los alimentos.
El diseño de los planes de control debe estar basado en un pormenorizado análisis de peligros, a partir del cual podremos determinar los análisis a realizar y su frecuencia, para controlar los puntos críticos que lo requieran. En el extremo, para garantizar la seguridad lote a lote, algunas empresas implementan sistemas de liberación positiva, que consisten en bloquear la liberación de lotes de producción hasta obtener la confirmación analítica de la inocuidad de cada uno de ellos.
Al objeto de obtener un nivel elevado de protección de la salud pública, el Reglamento (UE) Nº2073/2005 establece los criterios microbiológicos aplicables a los productos alimenticios, debiendo las empresas agroalimentarias cumplirlos, a lo largo de toda la cadena de alimentación, desde el proceso de fabricación, hasta la expedición del producto. Este reglamento dispone que los productos alimenticios no deben contener microorganismos ni sus toxinas o metabolitos en cantidades que supongan un riesgo inaceptable para la salud humana.
Para dar respuesta a estas necesidades, los operadores alimentarios necesitan disponer de una oferta analítica de las máximas garantías, aspecto este en el que la acreditación juega un papel determinante, además de suficientemente rápidos para que el control sea eficaz, especialmente cuando se implantan sistemas de control con liberación positiva de lotes.
| Responsable | AINIA |
| Domicilio | Calle Benjamín Franklin, 5 a 11, CP 46980 Paterna (Valencia) |
| Finalidad | Atender, registrar y contactarle para resolver la solicitud que nos realice mediante este formulario de contacto |
| Legitimación | Sus datos serán tratados solo con su consentimiento, al marcar la casilla mostrada en este formulario |
| Destinatarios | Sus datos no serán cedidos a terceros |
| Derechos | Tiene derecho a solicitarnos acceder a sus datos, corregirlos o eliminarlos, también puede solicitarnos limitar su tratamiento, oponerse a ello y a la portabilidad de sus datos, dirigiéndose a nuestra dirección postal o a privacy@ainia.es |
| Más info | Dispone de más información en nuestra Política de Privacidad |
| DPD | Si tiene dudas sobre como trataremos sus datos o quiere trasladar alguna sugerencia o queja, contacte al Delegado de protección de datos en info@businessadapter.es o en el Formulario de atención al interesado |
Consiento el uso de mis datos personales para que atiendan mi solicitud, según lo establecido en su Política de Privacidad.
Consiento el uso de mis datos para recibir información y comunicaciones comerciales de su entidad.
